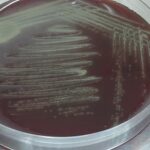
Gemella morbillorum -Introduction, Morphology, Pathogenicity, Lab Diagnosis, Treatment, Prevention, and Keynotes

Tag: Immunocompromised Hosts
Fungal Identification by Artificial Intelligence (AI): Introduction, Working Mechanisms, Clinical Significance, and Keynotes
 Introduction of Fungal Identification by Artificial Intelligence (AI) Fungal infections represent...
Introduction of Fungal Identification by Artificial Intelligence (AI) Fungal infections represent...
Gemella morbillorum -Introduction, Morphology, Pathogenicity, Lab Diagnosis, Treatment, Prevention, and Keynotes
Introduction "Gemella morbillorum" is a species within the genus Gemella,...
Introduction "Gemella morbillorum" is a species within the genus Gemella,...
